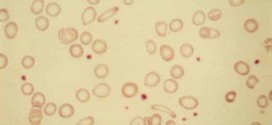

La hepatitis A (VHA). Se Caracterizada clínicamente por malestar, nauseas, vómitos, diarrea y fiebre, con orina oscura, ictericia y hígado grande doloroso; puede ser subclinica y detectarse por la elevación de las transaminasas (AST y ALT). El acusado es un virus, picomavirus (hepatovirus) de 27nm, con un genoma de ARN monocatenario. Transmisión fecal-oral, endémica en países subdesarrollados, a saber; epidemias …
Leer MásH
HIDRADENITIS O HIDRODENITIS SUPURATIVA
La hidradenitis supurativa. Se trata de un proceso inflamatorio supurativo y crónico (a saber) que afecta a las áreas cutáneas con glándulas sudoríperas apocrinas. La sucesión de estos episodios inflamatorios conduce a la destrucción de los apéndices cutáneos de estas zonas, cicatrización parcial y formación de fistulas. La enfermedad no se observa hasta después de la pubertad, momento en el …
Leer MásHIPERCALCEMIA NEOPLÁSICA
La hipercalcemia neoplásica. Se trata del síndrome paraneoplásico más frecuente; hipercalcemia de los tumores malignos supone el 40% de todas hipercalcemias. El 80% de los pacientes de cáncer con hipercalcemia sufren hipercalcemia humoral mediada por el péptido relacionado con la hormona paratiroidea; el 20% tiene hipercalcemia por osteólisis local mediada por citocinas como la interleucina y el factor de necrosis …
Leer MásHISTIOCITOMA FIBROSO MALIGNO (MFH)
El histiocitoma fibroso maligno (MFH). Histiocitoma fibroso maligno (MFH) es un tumor pleomórfico de alto grado formado por fibroblastos, miofibroblastos e histiocitos. HFM es el tumor de tejidos blandos más frecuente en adultos. MFH se encuentra en la extremidad inferior. Otros sitios menos comunes son el retroperitoneo, y la cabeza y el cuello. La mayor incidencia es durante la quinta …
Leer MásHIPOCROMÍA
La hipocromía. Estado en el que se observa una disminución de la pigmentación cutánea. Coloración o pigmentación disminuida e deficiente o disminución del contenido en hemoglobina de los eritrocitos. La causa más común de hipocromía en los Estados Unidos es la deficiencia de hierro. La hipocrómica es un tipo extremadamente raro de anemia, una enfermedad que consiste en una deficiencia …
Leer MásHIPERRESPUESTA BRONQUIAL (HRB)
La hiperrespuesta bronquial (HRB). Enfermedad caracterizada por ataques de disnea respiratoria de duración variable con sibilancias y sensación de constricción debida a espasmo bronquial. Reactividad aumentada de las vías respiratorias inferiores a numerosos estímulos: proceso episódico acompañado de obstrucción reversible. Los sintomas más frecuentes son: sibilancias, disnea, fiebre, tos, expectoración, taquicardia, taquipnea, cianosis, insuficiencia de la respiración, hiperinsuflacion, etc. Información: …
Leer MásHIPERINSULINISMO
El hiperinsulinismo. La causa se desconoce o no se conoce perfectamente, a saber. Su fisiopatología es extremadamente compleja y solo ha sido dilucidada algunas partes de ella. Por: Salvador Gregori, binipatia.com Resumiendo: La mayoría de estos enfermos tienen una edad algo mayor, son obesos, sedentarios, hipertensión, colesterol y tienen cierto grado de resistencia a la insulina. La resistencia a la …
Leer MásHIPERCROMÍA
La hipercromía. Estado en el que se observa un incremento de una pigmentación excesiva anormal de la piel, congénitas o adquiridas, como en las personas afectadas de cloasma y melanodermia, entre otras. Se opone a hipocromía. La hipercromía es un trastorno muy común en la piel y aunque puede afectar a cualquier persona, se presenta con mayor frecuencia en mujeres …
Leer MásHEPATOCARCINOMA FIBROLAMELAR
El hepatocarcinoma fibrolamelar. Tumor maligno en general y especialmente el formado por células epiteliales, a saber. Durante los primeros años de vida de una persona, las células normales se dividen más rápidamente para permitir el crecimiento. El cuerpo está compuesto por billones de células vivas. Las células normales del cuerpo crecen, se dividen formando nuevas células y mueren de manera …
Leer MásHEPATOMA
El hepatoma. Tumor maligno en general y especialmente el formado por células epiteliales, a saber. El hígado está situado en la parte superior derecha de la cavidad abdominal, debajo del diafragma y por encima del estómago, el riñón derecho y los intestinos. El hígado tiene forma cónica, es de color marrón rojizo oscuro y pesa alrededor de 3 libras. El …
Leer MásHIDROA
La hidroa. Enfermedad cutánea caracterizada por la erupción cutánea de vesículas o flictenas sobre manchas rojas e irregulares, producida por una fotosensibilización de la piel. Suele afectar a niños y jóvenes durante la primavera y el verano, cuando la incidencia de los rayos solares es mayor. Pues bien una vez diagnosticado cual es la enfermedad o nombre de dicha patología, …
Leer MásHERPES OFTÁLMICO
El herpes oftálmico. Es una enfermedad causada por la reactivación del virus de la varicela zoster (VVZ, herpesvirus), es morfológicamente idéntico al virus de la varicela pero antigénicamente distinto. El cuadro clínico de la varicela es diferente del herpes zoster (VHZ). El herpes es una enfermedad frecuente causado por la reactivación del virus de la varicela zoster, un virus de …
Leer MásHEPATITIS D
La hepatitis D (VHD, AGENTE DELTA), es la inflamación del hígado. Actualmente el virus infecta a 15 millones de personas en todo el mundo, casi todos adultos, y es muy común entre grupos de usuarios de drogas inyectadas y en los países que bordean el Mediterráneo. La mayoría de los niños con infección por VHD habitan en Italia y Grecia, …
Leer MásHIPERTENSIÓN
La hipertensión o hipertensión esencial. Aumento del tono tensión en general; especialmente aumento de la presión vascular o sanguínea. De ello se derivan algunas cifras medias hipertensión en el hombre: de 40 años: 14/8; de 50 años: 15/8,5; de 60 años: 16/9; de 70 años: 17/9,5; de 75 años: 17,5/9,75; de 80 años: 18/10. En la mujer: de 40 años: …
Leer MásHIPERPLASIA ADENOMATOSA QUÍSTICA DEL ENDOMETRIO
La hiperplasia adenomatosa quística del endometrio. El endometrio se divide en endometrio basal y endometrio funcional. El basal no responde a la progesterona y no se descama. A partir de él se regenera la mucosa. El funcional responde a la progesterona y se descama en la menstruación. La mitad superior de la funcional forma la capa compacta en la fase …
Leer MásHEPATITIS B
La hepatitis B (VHB). Constituye un importante problema de salud a nivel mundial y es el tipo más grave de hepatitis viral. Es sumamente recomendado el uso de la Trofología, para esta patología. Puede causar hepatopatía crónica y conlleva un alto riesgo de muerte por cirrosis y cáncer hepático. Es muy conveniente el usar la Trofología, para evitar esto. La exposición puede …
Leer MásHIRSUTISMO
El hirsutismo. El hirsutismo es el crecimiento excesivo de pelo terminal oscuro y denso en mujeres, normalmente en áreas andrógeno-dependientes. La causa es el aumento de producción de andrógenos o el aumento de la sensibilidad de los folículos pilosos a los andrógenos. Existen tres formas de presentarse este trastorno: por alteración funcional, por neoplasias, o inducido por medicamentos (fármacos). Causas: …
Leer MásHIPERTENSION ARTERIAL
La hipertensión arterial. Aumento del tono tensión en general; especialmente aumento de la presión vascular o sanguínea. De ello se derivan algunas cifras medias hipertensión en el hombre: de 40 años: 14/8; de 50 años: 15/8,5; de 60 años: 16/9; de 70 años: 17/9,5; de 75 años: 17,5/9,75; de 80 años: 18/10. En la mujer: de 40 años: 13/7,5; de …
Leer MásHEPATITIS C (VHC)
La hepatitis C (VHC), es la inflamación del hígado, por causa vírica. Resumiendo: Causada por el virus análogo a los flavivirus, con un genoma de ARN de más de 9000 nucleótidos (parecido a los virus del dengue y de la fiebre amarilla); cierta heterogeneidad genética. La infección de hepatitis C es causada por el virus de la hepatitis C (VHC). …
Leer MásHIPERTENSION ARTERIAL MALIGNA
La hipertensión arterial maligna. Aumento del tono tensión en general; especialmente aumento de la presión vascular o sanguínea. De ello se derivan algunas cifras medias hipertensión arterial en el hombre: de 40 años: 14/8; de 50 años: 15/8,5; de 60 años: 16/9; de 70 años: 17/9,5; de 75 años: 17,5/9,75; de 80 años: 18/10. En la mujer: de 40 años: …
Leer Más Binipatia e higienismo Medicina natural alternativa, plantas medicinales y remedios caseros naturales
Binipatia e higienismo Medicina natural alternativa, plantas medicinales y remedios caseros naturales